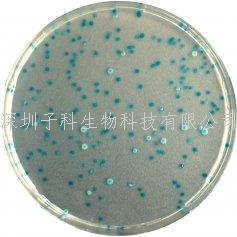

热门关键词: ELISA试剂盒 - 大鼠ELISA试剂盒- 小鼠ELISA试剂盒
全国统一客服热线:
0755-28715175
热门关键词: ELISA试剂盒 - 大鼠ELISA试剂盒- 小鼠ELISA试剂盒
全国统一客服热线:
0755-28715175

科马嘉大肠杆菌显色培养基
产品货号和规格:
1000ml..........EC166
5000ml..........EC168
25L...............EC169-25
按要求包装
用途:用于检测和计数食物和水样中的大肠杆菌
微生物的典型外观
大肠杆菌→蓝色
其他革兰阴性菌→无色
革兰氏阳性→抑制
培养基性能:
24小时检测.
易于解读: 一般食物和水标准限值是零到每克一个大肠杆菌菌落,因此准确检测并计数变得非常重要。使用 CHROMagar E.coli ,大肠杆菌菌落很快长成深蓝色 - 从而使检测并计数这一重要卫生指标变得尽可能简单。
工作量小: 传统的大肠杆菌检测方法是非常繁琐和劳累的,需要许多实验研究菌落。
质量高: CHROMagar 培养基比市场上其他培养基琼脂含量高5%。这有助于应用和样品划到板上。

0755-28715175/33164177

粤公网安备 44030902000304号